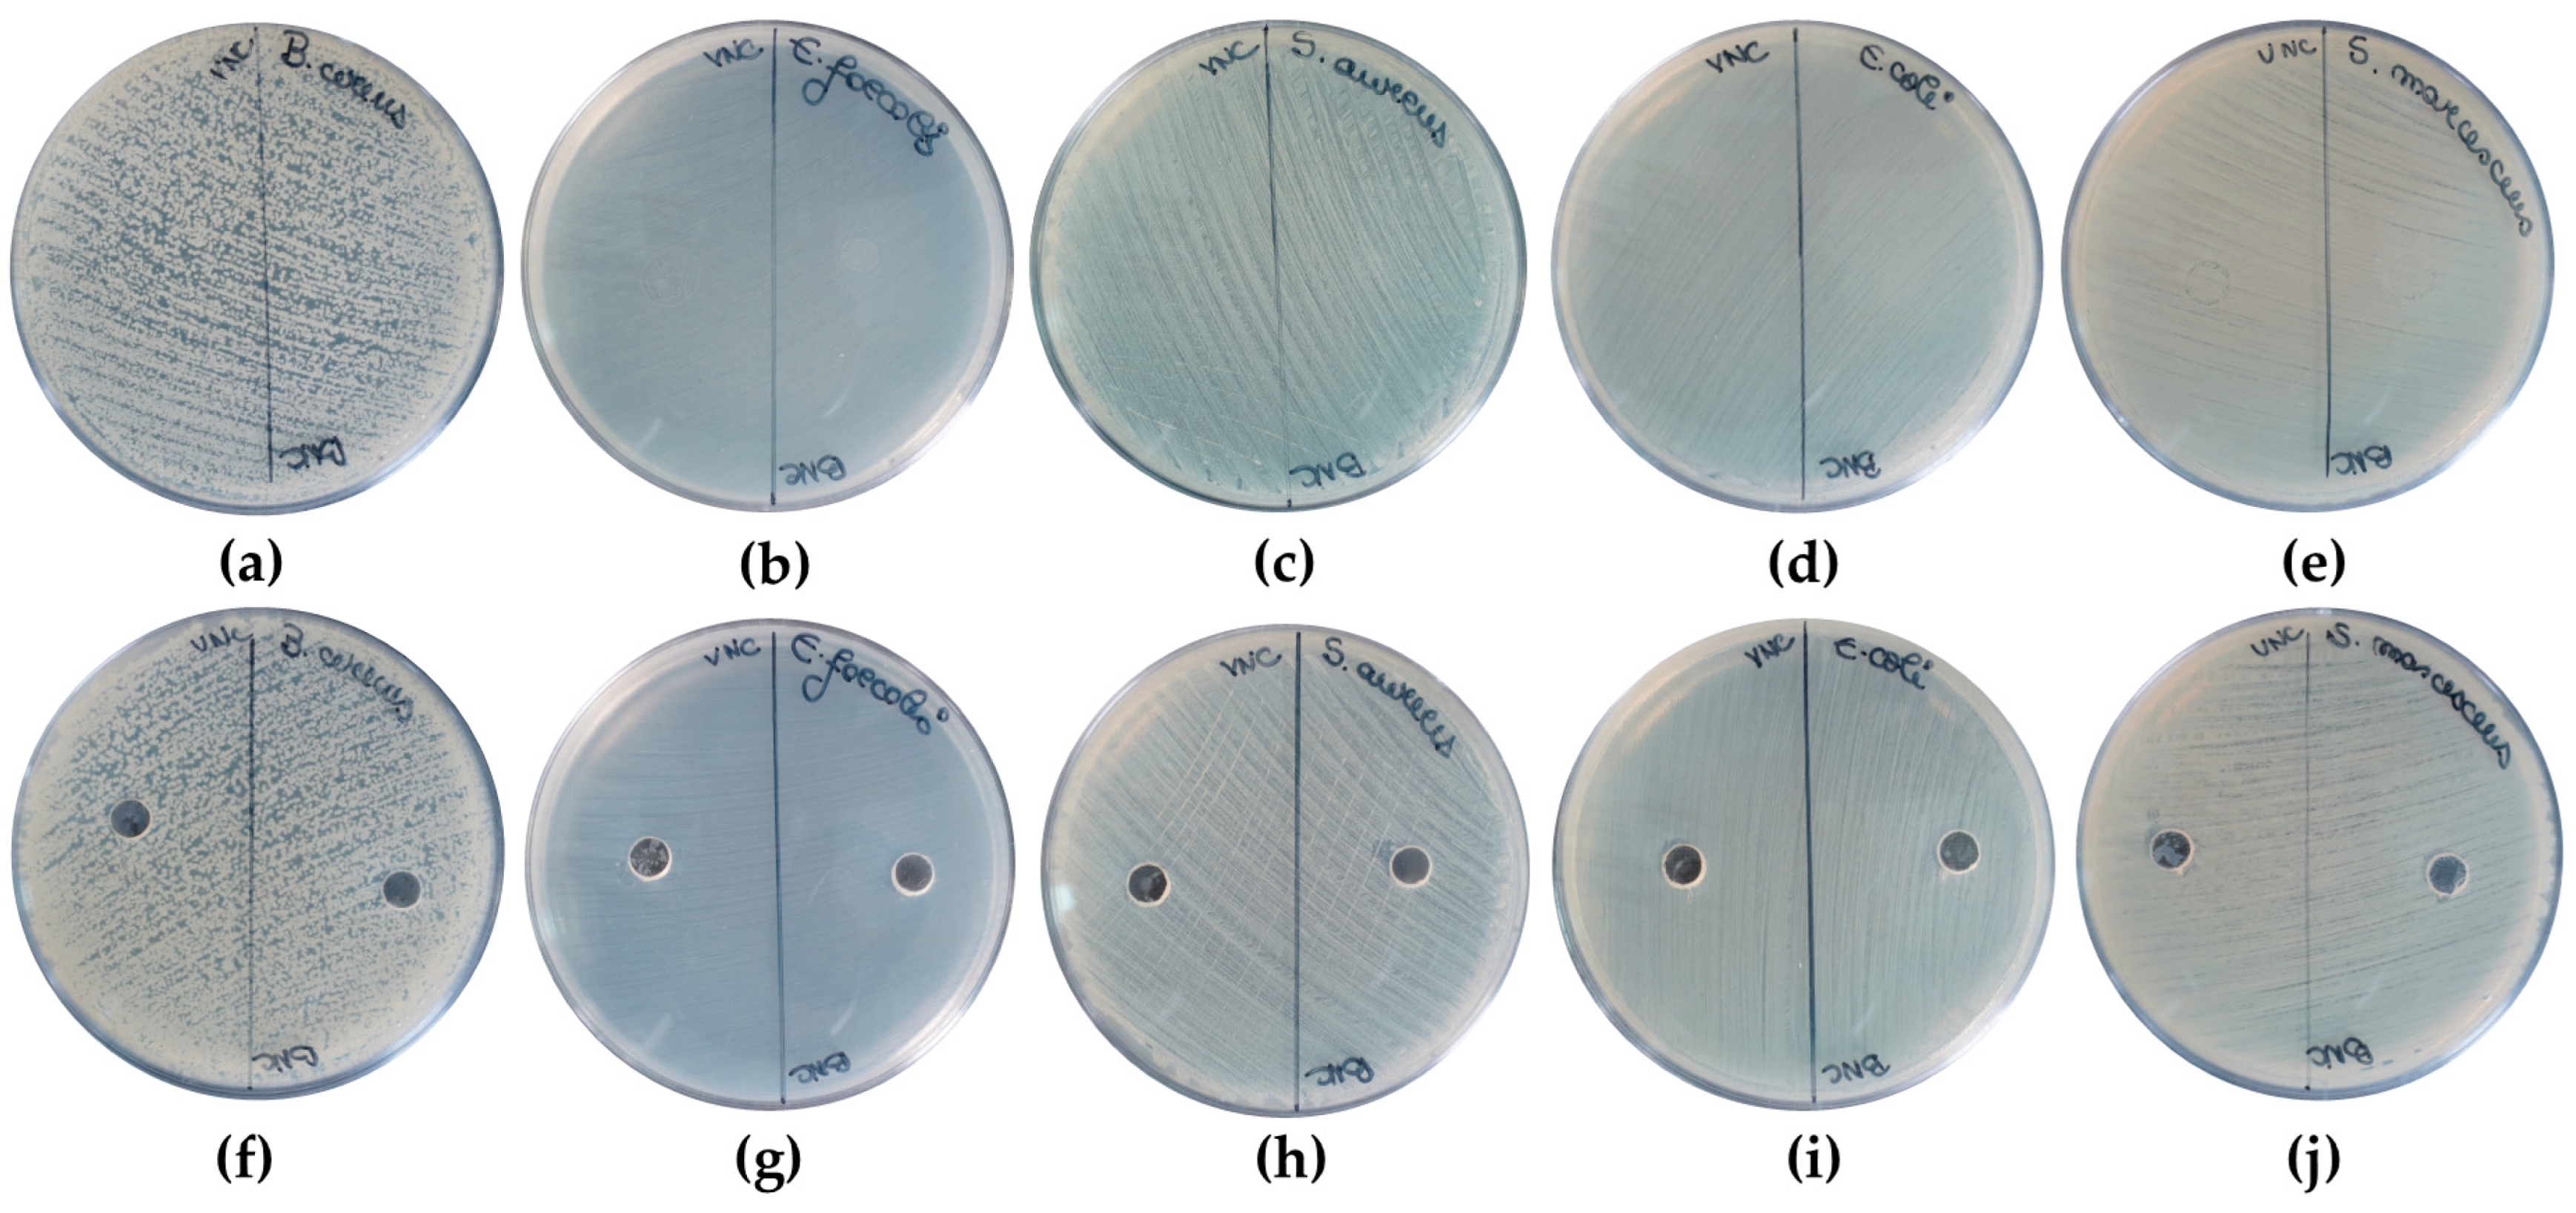
Gels 11 00037 g014

Kombucha Versus Vegetal Cellulose for Affordable Mucoadhesive (nano)Formulations
Abstract
1. Introduction
2. Results and Discussion
2.1. Morphological and Structural Aspects of Nanocellulose-Based Hydrogels and Hydrogel–Mucin Systems
2.2. Physicochemical Properties of Nanocelullose-Based Hydrogels and Hydrogel–Mucin Systems
2.3. The Cytocompatible Behavior of Nanocellulose-Based Hydrogels
3. Conclusions
4. Materials and Methods
4.1. Materials
4.2. Production of Bacterial Cellulose
4.3. Production of Bacterial and Vegetal Cellulose Nanofibers
4.4. Preparation of VNC-/BNC Hydrogels, and Hydrogel–Mucin Systems
4.5. Physico-Chemical Characterization of the VNC/BNC Hydrogels and Investigation of the Hydrogel–Mucin Interaction
4.5.1. Transmission Electron Microscopy (TEM) Analysis
4.5.2. Scanning Electron Microscopy (SEM) Analysis
4.5.3. X-Ray Diffraction (XRD) Analysis
4.5.4. Interfacial Tension and Contact Angle Assessment
4.5.5. Investigation of Mucin Binding Efficiency by Periodic acid Schiff (PAS) Assay
4.5.6. Rheological Analysis
4.5.7. Antioxidant Activity Assessment by DPPH and Potassium Ferricyanide Reducing Power (PFRAP) Assays
4.5.8. Fourier Transform Infrared Spectroscopy Analysis
4.5.9. Porosity Analysis
4.6. Biological Activity of VNC and BNC
4.6.1. Cytocompatibility Analysis by Cell Counting Kit-8 (CCK-8) and LIVE/DEAD Assays
4.6.2. Investigation of Cell Morphology
4.6.3. In Vitro Antioxidant Activity
4.6.4. Antibacterial Activity
4.7. Statistical Analysis
Author Contributions
Funding
Institutional Review Board Statement
Informed Consent Statement
Data Availability Statement
Acknowledgments
Conflicts of Interest
References
- Scrivener, C.A.; Schantz, C.W. Penicillin: New Methods for its Use in Dentistry. J. Am. Dent. Assoc. 1947, 35, 644–647. [Google Scholar] [CrossRef] [PubMed]
- Smart, J.D. The basics and underlying mechanisms of mucoadhesion. Adv. Drug Deliv. Rev. 2005, 57, 1556–1568. [Google Scholar] [CrossRef]
- Grondin, J.A.; Kwon, Y.H.; Far, P.M.; Haq, S.; Khan, W.I. Mucins in Intestinal Mucosal Defense and Inflammation: Learning From Clinical and Experimental Studies. Front. Immunol. 2020, 11, 2054. [Google Scholar] [CrossRef]
- Bird, D.; Ravindra, N.M. Transdermal drug delivery and patches—An overview. Med. Devices Sens. 2020, 3, e10069. [Google Scholar] [CrossRef]
- Rath, R.; Tevatia, S.; Rath, A.; Behl, A.; Modgil, V.; Sharma, N. Mucoadhesive Systems in Dentistry: A Review. Indian. J. Dent. Res. 2016, 4, 25–29. [Google Scholar] [CrossRef]
- Sharma, R.; Kumar, S.; Malviya, R.; Prajapati, B.G.; Puri, D.; Limmatvapirat, S.; Sriamornsak, P. Recent advances in biopolymer-based mucoadhesive drug delivery systems for oral application. J. Drug Deliv. Sci. Technol. 2024, 91, 105227. [Google Scholar] [CrossRef]
- Roy, S.; Pal, K.; Anis, A.; Pramanik, K.; Prabhakar, B. Polymers in Mucoadhesive Drug-Delivery Systems: A Brief Note. Des. Monomers Polym. 2009, 12, 483–495. [Google Scholar] [CrossRef]
- Sandri, G.; Rossi, S.; Ferrari, F.; Bonferoni, M.C.; Caramella, C.M. Mucoadhesive Polymers as Enabling Excipients for Oral Mucosal Drug Delivery. In Oral Mucosal Drug Delivery and Therapy; Rathbone, M.J., Senel, S., Pather, I., Eds.; Springer US: Boston, MA, USA, 2015; pp. 53–88. [Google Scholar]
- McFarlane, H.E.; Döring, A.; Persson, S. The cell biology of cellulose synthesis. Annu. Rev. Plant Biol. 2014, 65, 69–94. [Google Scholar] [CrossRef] [PubMed]
- Jayaramudu, T.; Ko, H.-U.; Kim, H.C.; Kim, J.W.; Choi, E.S.; Kim, J. Adhesion properties of poly (ethylene oxide)-lignin blend for nanocellulose composites. Compos. Part. B Eng. 2019, 156, 43–50. [Google Scholar] [CrossRef]
- Kontturi, K.S.; Biegaj, K.; Mautner, A.; Woodward, R.T.; Wilson, B.P.; Johansson, L.-S.; Lee, K.-Y.; Heng, J.Y.; Bismarck, A.; Kontturi, E. Noncovalent surface modification of cellulose nanopapers by adsorption of polymers from aprotic solvents. Langmuir 2017, 33, 5707–5712. [Google Scholar] [CrossRef] [PubMed]
- Ramírez, J.A.Á.; Hoyos, C.G.; Arroyo, S.; Cerrutti, P.; Foresti, M.L. Acetylation of bacterial cellulose catalyzed by citric acid: Use of reaction conditions for tailoring the esterification extent. Carbohydr. Polym. 2016, 153, 686–695. [Google Scholar] [CrossRef] [PubMed]
- Mishra, R.; Sabu, A.; Tiwari, S. Materials chemistry and the futurist eco-friendly applications of nanocellulose: Status and prospect. J. Saudi Chem. Soc. 2018, 22, 949–978. [Google Scholar] [CrossRef]
- Tan, H.; Marra, K.G. Injectable, biodegradable hydrogels for tissue engineering applications. Materials 2010, 3, 1746–1767. [Google Scholar] [CrossRef]
- Bi, L.; Cheng, W.; Fan, H.; Pei, G. Reconstruction of goat tibial defects using an injectable tricalcium phosphate/chitosan in combination with autologous platelet-rich plasma. Biomaterials 2010, 31, 3201–3211. [Google Scholar] [CrossRef]
- Li, H.; Ji, Q.; Chen, X.; Sun, Y.; Xu, Q.; Deng, P.; Hu, F.; Yang, J. Accelerated bony defect healing based on chitosan thermosensitive hydrogel scaffolds embedded with chitosan nanoparticles for the delivery of BMP2 plasmid DNA. J. Biomed. Mater. Res. Part. A 2017, 105, 265–273. [Google Scholar] [CrossRef]
- Alimardani, Y.; Mirzakhani, E.; Ansari, F.; Pourjafar, H.; Sadeghi, N. Prospective and applications of bacterial nanocellulose in dentistry. Cellulose 2024, 31, 7819–7839. [Google Scholar] [CrossRef]
- Revin, V.V.; Liyaskina, E.V.; Parchaykina, M.V.; Kuzmenko, T.P.; Kurgaeva, I.V.; Revin, V.D.; Ullah, M.W. Bacterial Cellulose-Based Polymer Nanocomposites: A Review. Polymers 2022, 14, 4670. [Google Scholar] [CrossRef] [PubMed]
- Horue, M.; Silva, J.M.; Berti, I.R.; Brandão, L.R.; Barud, H.D.S.; Castro, G.R. Bacterial Cellulose-Based Materials as Dressings for Wound Healing. Pharmaceutics 2023, 15, 424. [Google Scholar] [CrossRef] [PubMed]
- Shrivastav, P.; Pramanik, S.; Vaidya, G.; Abdelgawad, M.A.; Ghoneim, M.M.; Singh, A.; Abualsoud, B.M.; Amaral, L.S.; Abourehab, M.A.S. Bacterial cellulose as a potential biopolymer in biomedical applications: A state-of-the-art review. J. Mater. Chem. B 2022, 10, 3199–3241. [Google Scholar] [CrossRef]
- Razavi, S.; Janfaza, S.; Tasnim, N.; Gibson, D.L.; Hoorfar, M. Nanomaterial-based encapsulation for controlled gastrointestinal delivery of viable probiotic bacteria. Nanoscale Adv. 2021, 3, 2699–2709. [Google Scholar] [CrossRef]
- Das, M.; Lalsangi, S.; Santra, S.; Banerjee, R. Nanocellulose as a carrier for improved drug delivery: Progresses and innovation. J. Drug Deliv. Sci. Technol. 2024, 97, 105743. [Google Scholar] [CrossRef]
- Yoshino, A.; Tabuchi, M.; Uo, M.; Tatsumi, H.; Hideshima, K.; Kondo, S.; Sekine, J. Applicability of bacterial cellulose as an alternative to paper points in endodontic treatment. Acta Biomater. 2013, 9, 6116–6122. [Google Scholar] [CrossRef] [PubMed]
- Xiros, C.; Christakopoulos, P. Biotechnological potential of brewers spent grain and its recent applications. Waste Biomass Valorization 2012, 3, 213–232. [Google Scholar] [CrossRef]
- Pabbathi, N.P.P.; Velidandi, A.; Pogula, S.; Gandam, P.K.; Baadhe, R.R.; Sharma, M.; Sirohi, R.; Thakur, V.K.; Gupta, V.K. Brewer’s spent grains-based biorefineries: A critical review. Fuel 2022, 317, 123435. [Google Scholar] [CrossRef]
- Hindi, S.S.Z. Microcrystalline cellulose: The inexhaustible treasure for pharmaceutical industry. Nanosci. Nanotechnol. Res. 2017, 4, 17–24. [Google Scholar]
- Ahmadi Heidari, N.; Fathi, M.; Hamdami, N.; Taheri, H.; Siqueira, G.; Nyström, G. Thermally Insulating Cellulose Nanofiber Aerogels from Brewery Residues. ACS Sustain. Chem. Eng. 2023, 11, 10698–10708. [Google Scholar] [CrossRef]
- Tritean, N.; Dimitriu, L.; Dima, Ș.-O.; Ghiurea, M.; Trică, B.; Nicolae, C.-A.; Moraru, I.; Nicolescu, A.; Cimpean, A.; Oancea, F.; et al. Bioactive Hydrogel Formulation Based on Ferulic Acid-Grafted Nano-Chitosan and Bacterial Nanocellulose Enriched with Selenium Nanoparticles from Kombucha Fermentation. J. Funct. Biomater. 2024, 15, 202. [Google Scholar] [CrossRef] [PubMed]
- Dima, S.-O.; Panaitescu, D.-M.; Orban, C.; Ghiurea, M.; Doncea, S.-M.; Fierascu, R.C.; Nistor, C.L.; Alexandrescu, E.; Nicolae, C.-A.; Trică, B.; et al. Bacterial Nanocellulose from Side-Streams of Kombucha Beverages Production: Preparation and Physical-Chemical Properties. Polymers 2017, 9, 374. [Google Scholar] [CrossRef] [PubMed]
- Kaur, P.; Sharma, N.; Munagala, M.; Rajkhowa, R.; Aallardyce, B.; Shastri, Y.; Agrawal, R. Nanocellulose: Resources, Physio-Chemical Properties, Current Uses and Future Applications. Front. Nanotechnol. 2021, 3, 747329. [Google Scholar] [CrossRef]
- Jonoobi, M.; Oladi, R.; Davoudpour, Y.; Oksman, K.; Dufresne, A.; Hamzeh, Y.; Davoodi, R. Different preparation methods and properties of nanostructured cellulose from various natural resources and residues: A review. Cellulose 2015, 22, 935–969. [Google Scholar] [CrossRef]
- Baig, N.; Kammakakam, I.; Falath, W. Nanomaterials: A review of synthesis methods, properties, recent progress, and challenges. Mater. Adv. 2021, 2, 1821–1871. [Google Scholar] [CrossRef]
- Khalil, H.A.; Jummaat, F.; Yahya, E.B.; Olaiya, N.G.; Adnan, A.S.; Abdat, M.; N.A.M., N.; Halim, A.S.; Kumar, U.S.U.; Bairwan, R.; et al. A Review on Micro- to Nanocellulose Biopolymer Scaffold Forming for Tissue Engineering Applications. Polymers 2020, 12, 2043. [Google Scholar] [CrossRef] [PubMed]
- Tamo, A.K. Nanocellulose-based hydrogels as versatile materials with interesting functional properties for tissue engineering applications. J. Mater. Chem. B 2024, 12, 7692–7759. [Google Scholar] [CrossRef] [PubMed]
- Chinga-Carrasco, G. Cellulose fibres, nanofibrils and microfibrils: The morphological sequence of MFC components from a plant physiology and fibre technology point of view. Nanoscale Res. Lett. 2011, 6, 417. [Google Scholar] [CrossRef]
- Missoum, K.; Belgacem, M.N.; Bras, J. Nanofibrillated Cellulose Surface Modification: A Review. Materials 2013, 6, 1745–1766. [Google Scholar] [CrossRef]
- Zhao, G.; Du, J.; Chen, W.; Pan, M.; Chen, D. Preparation and thermostability of cellulose nanocrystals and nanofibrils from two sources of biomass: Rice straw and poplar wood. Cellulose 2019, 26, 8625–8643. [Google Scholar] [CrossRef]
- Lin, Y.-J.; Shatkin, J.A.; Kong, F. Evaluating mucoadhesion properties of three types of nanocellulose in the gastrointestinal tract in vitro and ex vivo. Carbohydr. Polym. 2019, 210, 157–166. [Google Scholar] [CrossRef] [PubMed]
- Marrinan, H.J.; Mann, J. Infrared spectra of the crystalline modifications of cellulose. J. Polym. Sci. 1956, 21, 301–311. [Google Scholar] [CrossRef]
- Vanderhart, D.L.; Atalla, R.H. Studies of microstructure in native celluloses using solid-state C-13 NMR. Macromolecules 1984, 17, 1465–1472. [Google Scholar] [CrossRef]
- Sugiyama, J.; Persson, J.; Chanzy, H. Combined infrared and electron-diffraction study of the polymorphism of native celluloses. Macromolecules 1991, 24, 2461–2466. [Google Scholar] [CrossRef]
- Wu, Z.; Chen, S.; Li, J.; Wang, B.; Jin, M.; Liang, Q.; Zhang, D.; Han, Z.; Deng, L.; Qu, X.; et al. Insights into Hierarchical Structure–Property–Application Relationships of Advanced Bacterial Cellulose Materials. Adv. Funct. Mater. 2023, 33, 2214327. [Google Scholar] [CrossRef]
- van Zyl, E.M.; Coburn, J.M. Hierarchical structure of bacterial-derived cellulose and its impact on biomedical applications. Curr. Opin. Chem. Eng. 2019, 24, 122–130. [Google Scholar] [CrossRef]
- Kadier, A.; Ilyas, R.A.; Huzaifah, M.R.M.; Harihastuti, N.; Sapuan, S.M.; Harussani, M.M.; Azlin, M.N.M.; Yuliasni, R.; Ibrahim, R.; Atikah, M.S.N.; et al. Use of Industrial Wastes as Sustainable Nutrient Sources for Bacterial Cellulose (BC) Production: Mechanism, Advances, and Future Perspectives. Polymers 2021, 13, 3365. [Google Scholar] [CrossRef]
- Moraru, A.; Dima, Ș.-O.; Tritean, N.; Oprița, E.-I.; Prelipcean, A.-M.; Trică, B.; Oancea, A.; Moraru, I.; Constantinescu-Aruxandei, D.; Oancea, F. Bioactive-Loaded Hydrogels Based on Bacterial Nanocellulose, Chitosan, and Poloxamer for Rebalancing Vaginal Microbiota. Pharmaceuticals 2023, 16, 1671. [Google Scholar] [CrossRef] [PubMed]
- Tritean, N.; Dima, Ș.-O.; Trică, B.; Stoica, R.; Ghiurea, M.; Moraru, I.; Cimpean, A.; Oancea, F.; Constantinescu-Aruxandei, D. Selenium-Fortified Kombucha–Pollen Beverage by In Situ Biosynthesized Selenium Nanoparticles with High Biocompatibility and Antioxidant Activity. Antioxidants 2023, 12, 1711. [Google Scholar] [CrossRef]
- Avgidou, M.; Dimopoulou, M.; Mackie, A.; Rigby, N.; Ritzoulis, C.; Panayiotou, C. Physicochemical aspects of mucosa surface. RSC Adv. 2016, 6, 102634–102646. [Google Scholar] [CrossRef]
- Lim, S.; Yong, G.; Chia, C.; Man, S.; Subramanian, G.; Oh, G.; Cheong, E.; Kiryukhin, M. Mucin coated protein-polyphenol microcarriers for daidzein delivery. Food Funct. 2024, 15, 2645–2654. [Google Scholar] [CrossRef] [PubMed]
- Ferreira, A.; Vikulina, A.; Bowker, L.; Hunt, J.; Loughlin, M.; Puddu, V.; Volodkin, D. Nanoarchitectonics of Bactericidal Coatings Based on CaCO3-Nanosilver Hybrids. ACS Appl. Biomater. 2024, 7, 2872–2886. [Google Scholar] [CrossRef] [PubMed]
- Tritean, N.; Dimitriu, L.; Dima, Ș.-O.; Stoica, R.; Trică, B.; Ghiurea, M.; Moraru, I.; Cimpean, A.; Oancea, F.; Constantinescu-Aruxandei, D. Cytocompatibility, Antimicrobial and Antioxidant Activity of a Mucoadhesive Biopolymeric Hydrogel Embedding Selenium Nanoparticles Phytosynthesized by Sea Buckthorn Leaf Extract. Pharmaceuticals 2024, 17, 23. [Google Scholar] [CrossRef] [PubMed]
- Hinterstoisser, B.; Åkerholm, M.; Salmén, L. Effect of fiber orientation in dynamic FTIR study on native cellulose. Carbohydr. Res. 2001, 334, 27–37. [Google Scholar] [CrossRef] [PubMed]
- Ibrahim, M.; Osman, O.; Mahmoud, A.A. Spectroscopic analyses of cellulose and chitosan: FTIR and modeling approach. J. Comput. Theor. Nanosci. 2011, 8, 117–123. [Google Scholar] [CrossRef]
- George, J.; Sajeevkumar, V.A.; Kumar, R.; Ramana, K.V.; Sabapathy, S.N.; Bawa, A.S. Enhancement of thermal stability associated with the chemical treatment of bacterial (Gluconacetobacter xylinus) cellulose. J. Appl. Polym. Sci. 2008, 108, 1845–1851. [Google Scholar] [CrossRef]
- Rose, M.C.; Voynow, J.A. Respiratory tract mucin genes and mucin glycoproteins in health and disease. Physiol. Rev. 2006, 86, 245–278. [Google Scholar] [CrossRef] [PubMed]
- Uthaiwat, P.; Priprem, A.; Puthongking, P.; Daduang, J.; Nukulkit, C.; Chio-Srichan, S.; Boonsiri, P.; Thapphasaraphong, S. Characteristic evaluation of gel formulation containing niosomes of melatonin or its derivative and mucoadhesive properties using ATR-FTIR spectroscopy. Polymers 2021, 13, 1142. [Google Scholar] [CrossRef] [PubMed]
- Miller, A.F.; Donald, A.M. Surface and Interfacial Tension of Cellulose Suspensions. Langmuir 2002, 18, 10155–10162. [Google Scholar] [CrossRef]
- de Amorim, J.D.P.; de Souza, K.C.; Duarte, C.R.; da Silva Duarte, I.; de Assis Sales Ribeiro, F.; Silva, G.S.; de Farias, P.M.A.; Stingl, A.; Costa, A.F.S.; Vinhas, G.M.; et al. Plant and bacterial nanocellulose: Production, properties and applications in medicine, food, cosmetics, electronics and engineering. A review. Environ. Chem. Lett. 2020, 18, 851–869. [Google Scholar] [CrossRef]
- Fazilati, M.; Ingelsten, S.; Wojno, S.; Nypelo, T.; Kadar, R. Thixotropy of cellulose nanocrystal suspensions. J. Rheol. 2021, 65, 1035–1052. [Google Scholar] [CrossRef]
- Moberg, T.; Sahlin, K.; Yao, K.; Geng, S.Y.; Westman, G.; Zhou, Q.; Oksman, K.; Rigdahl, M. Rheological properties of nanocellulose suspensions: Effects of fibril/particle dimensions and surface characteristics. Cellulose 2017, 24, 2499–2510. [Google Scholar] [CrossRef]
- Lawrence, C.; Zhou, W. Spin coating of non-Newtonian fluids. J. Non-Newton. Fluid Mech. 1991, 39, 137–187. [Google Scholar] [CrossRef]
- Stadler, F.; Piel, C.; Kaschta, J.; Rulhoff, S.; Kaminsky, W.; Münstedt, H. Dependence of the zero shear-rate viscosity and the viscosity function of linear high-density polyethylenes on the mass-average molar mass and polydispersity. Rheol. Acta 2006, 45, 755–764. [Google Scholar] [CrossRef]
- Carreau, P.J. Rheological Equations from Molecular Network Theories. Trans. Soc. Rheol. 1972, 16, 99–127. [Google Scholar] [CrossRef]
- Yasuda, K. Investigation of the Analogies Between Viscometric and Linear Viscoelastic Properties of Polystyrene Fluids. Ph.D. Thesis, Massachusetts Institute of Technology, Cambridge, MA, USA, 1979. [Google Scholar]
- Miyamoto, H.; Rein, D.M.; Ueda, K.; Yamane, C.; Cohen, Y. Molecular dynamics simulation of cellulose-coated oil-in-water emulsions. Cellulose 2017, 24, 2699–2711. [Google Scholar] [CrossRef]
- Biermann, O.; Hädicke, E.; Koltzenburg, S.; Müller-Plathe, F. Hydrophilicity and Lipophilicity of Cellulose Crystal Surfaces. Angew. Chem. Int. Ed. 2001, 40, 3822–3825. [Google Scholar] [CrossRef]
- KocevarNared, J.; Kristl, J.; SmidKorbar, J. Comparative rheological investigation of crude gastric mucin and natural gastric mucus. Biomaterials 1997, 18, 677–681. [Google Scholar] [CrossRef] [PubMed]
- Celli, J.P.; Turner, B.S.; Afdhal, N.H.; Ewoldt, R.H.; McKinley, G.H.; Bansil, R.; Erramilli, S. Rheology of gastric mucin exhibits a pH-dependent sol-gel transition. Biomacromolecules 2007, 8, 1580–1586. [Google Scholar] [CrossRef] [PubMed]
- Thommes, M.; Kaneko, K.; Neimark, A.V.; Olivier, J.P.; Rodriguez-Reinoso, F.; Rouquerol, J.; Sing, K.S.W. Physisorption of gases, with special reference to the evaluation of surface area and pore size distribution (IUPAC Technical Report). Pure Appl. Chem. 2015, 87, 1051–1069. [Google Scholar] [CrossRef]
- Kruk, M.; Jaroniec, M. Gas adsorption characterization of ordered organic-inorganic nanocomposite materials. Chem. Mater. 2001, 13, 3169–3183. [Google Scholar] [CrossRef]
- Bismarck, A.; Aranberri-Askargorta, I.; Springer, J.; Lampke, T.; Wielage, B.; Stamboulis, A.; Shenderovich, I.; Limbach, H. Surface characterization of flax, hemp and cellulose fibers; Surface properties and the water uptake behavior. Polym. Compos. 2002, 23, 872–894. [Google Scholar] [CrossRef]
- Guo, J.; Catchmark, J. Surface area and porosity of acid hydrolyzed cellulose nanowhiskers and cellulose produced by Gluconacetobacter xylinus. Carbohydr. Polym. 2012, 87, 1026–1037. [Google Scholar] [CrossRef]
- Fontes-Candia, C.; Erboz, E.; Martínez-Abad, A.; López-Rubio, A.; Martínez-Sanz, M. Superabsorbent food packaging bioactive cellulose-based aerogels from Arundo donax waste biomass. Food Hydrocoll. 2019, 96, 151–160. [Google Scholar] [CrossRef]
- Heise, K.; Delepierre, G.; King, A.W.T.; Kostiainen, M.A.; Zoppe, J.; Weder, C.; Kontturi, E. Chemical Modification of Reducing End-Groups in Cellulose Nanocrystals. Angew. Chem. Int. Ed. 2021, 60, 66–87. [Google Scholar] [CrossRef]
- Li, J.; Wang, X.; Chang, C.H.; Jiang, J.; Liu, Q.; Liu, X.; Liao, Y.-P.; Ma, T.; Meng, H.; Xia, T. Nanocellulose Length Determines the Differential Cytotoxic Effects and Inflammatory Responses in Macrophages and Hepatocytes. Small 2021, 17, 2102545. [Google Scholar] [CrossRef] [PubMed]
- Kandhola, G.; Park, S.; Lim, J.-W.; Chivers, C.; Song, Y.H.; Chung, J.H.; Kim, J.; Kim, J.-W. Nanomaterial-Based Scaffolds for Tissue Engineering Applications: A Review on Graphene, Carbon Nanotubes and Nanocellulose. Tissue Eng. Regen. Med. 2023, 20, 411–433. [Google Scholar] [CrossRef]
- Wang, X.; Chang, C.H.; Jiang, J.; Liu, Q.; Liao, Y.-P.; Lu, J.; Li, L.; Liu, X.; Kim, J.; Ahmed, A.; et al. The Crystallinity and Aspect Ratio of Cellulose Nanomaterials Determine Their Pro-Inflammatory and Immune Adjuvant Effects In Vitro and In Vivo. Small 2019, 15, 1901642. [Google Scholar] [CrossRef] [PubMed]
- Olennikov, D.N.; Kirillina, C.S.; Chirikova, N.K. Water-Soluble Melanoidin Pigment as a New Antioxidant Component of Fermented Willowherb Leaves (Epilobium angustifolium). Antioxidants 2021, 10, 1300. [Google Scholar] [CrossRef] [PubMed]
- Sava, V.M.; Yang, S.-M.; Hong, M.-Y.; Yang, P.-C.; Huang, G.S. Isolation and characterization of melanic pigments derived from tea and tea polyphenols. Food Chem. 2001, 73, 177–184. [Google Scholar] [CrossRef]
- Xu, Q.; Tao, W.; Ao, Z. Antioxidant activity of vinegar melanoidins. Food Chem. 2007, 102, 841–849. [Google Scholar] [CrossRef]
- Li, S.-M.; Jia, N.; Ma, M.-G.; Zhang, Z.; Liu, Q.-H.; Sun, R.-C. Cellulose–silver nanocomposites: Microwave-assisted synthesis, characterization, their thermal stability, and antimicrobial property. Carbohydr. Polym. 2011, 86, 441–447. [Google Scholar] [CrossRef]
- Casalini, S.; Baschetti, M.G.; Cappelletti, M.; Guerreiro, A.C.; Gago, C.M.; Nici, S.; Antunes, M.D. Antimicrobial activity of different nanocellulose films embedded with thyme, cinnamon, and oregano essential oils for active packaging application on raspberries. Front. Sustain. Food Syst. 2023, 7, 1190979. [Google Scholar] [CrossRef]
- Amarasekara, A.S.; Wang, D.; Grady, T.L. A comparison of kombucha SCOBY bacterial cellulose purification methods. SN Appl. Sci. 2020, 2, 1–7. [Google Scholar] [CrossRef]
- Mantle, M.; Allen, A. A Colorimetric Assay for Glycoproteins Based on the Periodic Acid/Schiff Stain. Biochem. Soc. Trans. 1978, 6, 607–609. [Google Scholar] [CrossRef]
- Hejjaji, E.; Smith, A.; Morris, G. Evaluation of the mucoadhesive properties of chitosan nanoparticles prepared using different chitosan to tripolyphosphate (CS:TPP) ratios. Int. J. Biol. Macromol. 2018, 120, 1610–1617. [Google Scholar] [CrossRef]
- Ciobanu, L.T.; Constantinescu-Aruxandei, D.; Tritean, N.; Lupu, C.; Negrilă, R.N.; Farcasanu, I.C.; Oancea, F. Valorization of Spent Brewer’s Yeast Bioactive Components via an Optimized Ultrasonication Process. Fermentation 2023, 9, 952. [Google Scholar] [CrossRef]
- Kim, H.; Xue, X. Detection of Total Reactive Oxygen Species in Adherent Cells by 2′,7′-Dichlorodihydrofluorescein Diacetate Staining. J. Vis. Exp. 2020, 160, e60682. [Google Scholar] [CrossRef]
- Suresh, S.; Karthikeyan, S.; Saravanan, P.; Jayamoorthy, K. Comparison of antibacterial and antifungal activities of 5-amino-2-mercaptobenzimidazole and functionalized NiO nanoparticles. Karbala Int. J. Mod. Sci. 2016, 2, 188–195. [Google Scholar] [CrossRef]

| Sample | Surface Tension (mN/m) | Contact Angle/Hydrophilic Surface (°) | Contact Angle/Hydrophobic Surface (°) | |||
|---|---|---|---|---|---|---|
| VNC * | 50.44 ± 0.66, d ** | ![]() | 52.70 ± 0.56, d | ![]() | 56.90 ± 0.40, a | ![]() |
| VNCMu | 46.22 ± 0.39, b (8.37 ± 0.78% decrease) | ![]() | 50.90 ± 0.03, c (3.42 ± 0.68% decrease) | ![]() | 58.14 ± 0.41, b (2.18 ± 0.73% increase) | ![]() |
| BNC | 55.29 ± 0.29, e | ![]() | 48.27 ± 0.57, b | ![]() | 65.13 ± 0.35, c | ![]() |
| BNCMu | 48.50 ± 0.54, c (12.28 ± 0.97% decrease) | ![]() | 46.53 ± 0.55, a (3.59 ± 1.14% decrease) | ![]() | 68.00 ± 0.26, d (4.40 ± 0.41% increase) | ![]() |
| Mu | 39.33 ± 0.47, a | ![]() | 45.67 ± 0.71, a | ![]() | 78.27 ± 0.45, e | ![]() |
| Sample | DPPH (µM TE/mg (Dry Weight) Hydrogel * | PFRAP (µM AAE/mg (Dry Weight) Hydrogel |
|---|---|---|
| VNC ** | 13.6 ± 2.6 | 15.5 ± 1.2 |
| BNC | 0 | 0 |
Disclaimer/Publisher’s Note: The statements, opinions and data contained in all publications are solely those of the individual author(s) and contributor(s) and not of MDPI and/or the editor(s). MDPI and/or the editor(s) disclaim responsibility for any injury to people or property resulting from any ideas, methods, instructions or products referred to in the content. |
© 2025 by the authors. Licensee MDPI, Basel, Switzerland. This article is an open access article distributed under the terms and conditions of the Creative Commons Attribution (CC BY) license (https://creativecommons.org/licenses/by/4.0/).
Share and Cite
Popa-Tudor, I.; Tritean, N.; Dima, Ș.-O.; Trică, B.; Ghiurea, M.; Cimpean, A.; Oancea, F.; Constantinescu-Aruxandei, D. Kombucha Versus Vegetal Cellulose for Affordable Mucoadhesive (nano)Formulations. Gels 2025, 11, 37. https://doi.org/10.3390/gels11010037
Popa-Tudor I, Tritean N, Dima Ș-O, Trică B, Ghiurea M, Cimpean A, Oancea F, Constantinescu-Aruxandei D. Kombucha Versus Vegetal Cellulose for Affordable Mucoadhesive (nano)Formulations. Gels. 2025; 11(1):37. https://doi.org/10.3390/gels11010037
Chicago/Turabian StylePopa-Tudor, Ioana, Naomi Tritean, Ștefan-Ovidiu Dima, Bogdan Trică, Marius Ghiurea, Anisoara Cimpean, Florin Oancea, and Diana Constantinescu-Aruxandei. 2025. "Kombucha Versus Vegetal Cellulose for Affordable Mucoadhesive (nano)Formulations" Gels 11, no. 1: 37. https://doi.org/10.3390/gels11010037
APA StylePopa-Tudor, I., Tritean, N., Dima, Ș.-O., Trică, B., Ghiurea, M., Cimpean, A., Oancea, F., & Constantinescu-Aruxandei, D. (2025). Kombucha Versus Vegetal Cellulose for Affordable Mucoadhesive (nano)Formulations. Gels, 11(1), 37. https://doi.org/10.3390/gels11010037
















